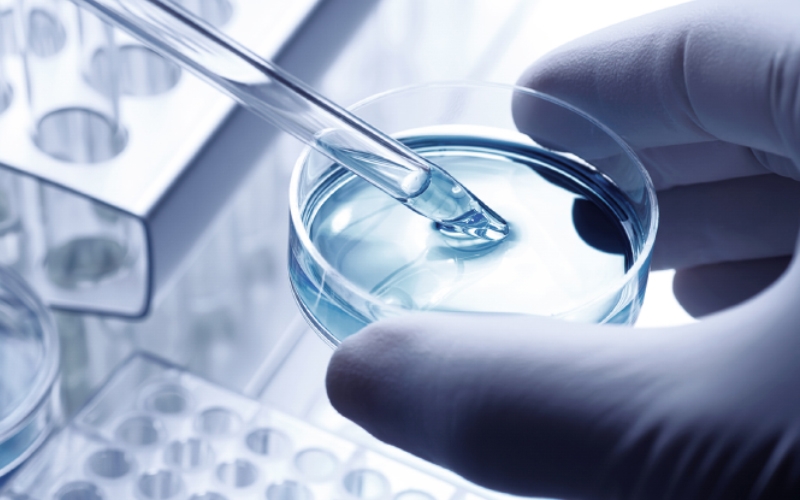

-
「油痘肌必看」伊膚泉泛痘肌系列全線產(chǎn)品,都在這集合了!
伊膚泉泛祛痘系列,就是基于痘肌問(wèn)題相互關(guān)聯(lián),先后發(fā)生的特性,緊密結(jié)合皮膚維養(yǎng)全周期管理,凝練而成的泛痘肌問(wèn)題解決方案。圍繞戰(zhàn)痘全周期,從祛痘痘-淡痘印-平痘痕-縮毛孔-痘肌維養(yǎng),一體化管理痘肌,一條龍...
23
2022.06
-
新品上市I痘坑別再瞎折騰!這款新平膚項(xiàng)目超有效!
不想被「痘坑」坑,最好的辦法是不踩坑!伊膚泉平膚修護(hù)組合,遠(yuǎn)想醫(yī)學(xué)研究院最新研發(fā),為痘坑專研,有效改善凹陷痘坑。...
02
2022.06
-
成分領(lǐng)銜,功效為先,伊膚泉7款家居產(chǎn)品全新更名上市啦!
伊膚泉根據(jù)《化妝品命名規(guī)定》,立足于產(chǎn)品成分及功效,結(jié)合多年臨床實(shí)踐、消費(fèi)者反饋、使用效果等,特對(duì)7款家居產(chǎn)品進(jìn)行了更名...
07
2022.05
聯(lián)系我們
聯(lián)系地址:廣州市海珠區(qū)新港東路2842號(hào)自編之三218遠(yuǎn)想集團(tuán)